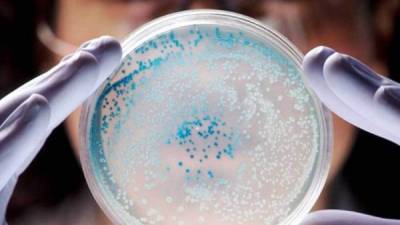
Foto: La Prensa

Las autoridades del estado de Luisiana, en Estados Unidos, analizan cómo una peligrosa y a menudo mortal bacteria fue encontrada al exterior del laboratorio de un centro de investigación de alta seguridad, informó el domingo el diario USA Today.
Las autoridades afirmaron a la publicación que la población no corre riesgo alguno, pero ignoran aún las dimensiones de la contaminación.
El incidente, que se produjo en el National Primate Research Center de Tulane, situado a unos 80 kms de Nueva Orleans, que trabaja sobre una vacuna contra esta bacteria, tuvo lugar en noviembre de 2014 o antes.
La bacteria en cuestión es llamada Burkholderia pseudomallei o bacilo de Whitmore. Se la encuentra principalmente en el sudeste asiático y en el norte de Australia. Puede transmitirse a humanos o a animales por contacto con el suelo o con agua contaminada.
Está clasificada en la categoría de los agentes que pueden ser utilizados en bioterrorismo.
Las autoridades señalaron que la bacteria no fue detectada en los terrenos pertenecientes al centro, a pesar de que cuatro monos que permanecían en locales exteriores enfermaron. Dos de ellos debieron ser sacrificados, informó el USA Today.
Una inspectora federal que visitó el centro también enfermó, pero es posible que haya estado expuesta a la bacteria anteriormente, ya que efectuó varios viajes al extranjero.
Según el centro de investigación, los monos habrían sido infectados durante un tratamiento en el hospital veterinario del complejo.
El director del centro, Andrew Lackner, dijo que 39 muestras del suelo y 13 muestras de agua provenientes de los terrenos del establecimiento habían sido analizadas, sin que se hallara rastro alguno de la bacteria.
Sin embargo, según el USA Today las muestras fueron insuficientes como para descartar por completo la presencia de la bacteria, que es de muy dificultosa detección. Los responsables científicos indicaron que las investigaciones al respecto deben proseguir.
'El hecho que las autoridades no puedan establecer cómo pudo producirse la difusión de la bacteria es muy preocupante', dijo al diario Richard Ebright, un experto en seguridad biológica de la Rutgers University, en Nueva Jersey.